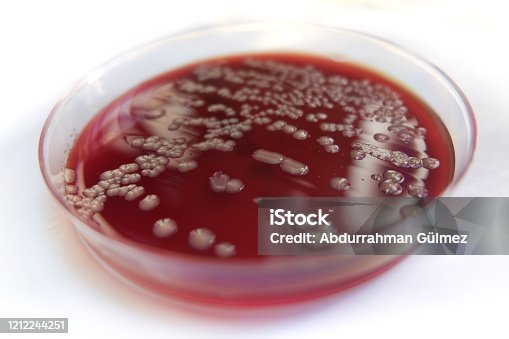

【50%OFF 94,800円 ⇒ 47,400円】 1/5(月)23:59まで|楽天1位 業界最高峰パワー VIOにも刺激レス 脱毛器・光美容器を手掛けるブラウン シルクエキスパート…

細菌ベータ hemolysis 羊の血液寒天培地 - ストックフォト・写真素材...

◆楽天1位◆【当店限定豪華6大特典】フードプロセッサー レコルト コードレス カプセルカッターボンヌ ブレンダー ミキサー ジェラート recolte 電動 大根おろし 氷も砕ける 小型…

臨床診断薬分野医療関係者向けサイト 製品・サービス微生物検査用精度管理用免疫血清学的検査用炎症性腸疾患COVID-19精度管理システム Ni-QCS(ニクシス)製品検索

★公式店限定 保証期間最大2年★【クレイツ公式】 コテ カールアイロン カールプロ SR クレイツ ヘアアイロン カール コテ 正規品 26mm 32mm 38mm 45mm CREATEs…

【正規品 】マキタ 掃除機 コードレス CL116DW 新品 日本製 1年保証 バッテリーセット 掃除機 ハンディ マキタ 充電式クリーナー マキタコードレスクリーナー コードレス掃除機マキタ…

福袋 2026 特賞 PS5 Switch2 ダイソン ズワイガニ タラバガニ 黒毛和牛 食品 お宝ワールド福袋 2026年 人気商品3点詰め込み ヒーター ###お宝ワールド福袋###

菌種別 Span Class P100italic Neisseria Span 属 微生物検査 検査 診断matrix

クーポンで6,180円【年間ランキング受賞】 加湿器 大容量 加湿器 卓上 6L 加湿機 ハイブリッド加湿器 加湿器 スチーム式 四重除菌 空気清浄機 卓上 オフィス 湿度設定 イオン除菌…

Incident ID: 4d7d7a31-bohn-4479-930b-6de49fd1a9ae IP Address : 219.104.25.38
血液寒天培地、プレート、文化、インフルエンザ、インフルエンザ、satelliting、黄色ブドウ球菌、黄色ブドウ球菌

【正規品】リファストレートアイロン プロ MTG ReFa ReFa STRAIGHT IRON PRO

\年末年始大感謝クーポンで最安2,677円/楽天1位 4冠達成 セラミックヒーター ファンヒーター 2秒速暖 小型 静音 省エネ おしゃれ 足元ヒーター 12畳部屋対応 転倒自動オフ…

【初売りセール】2026新モデル【2年保証】掃除機 コードレス掃除機 Orage史上 超高性能 RR11 軽量 人気 1位 自立 自走式 スティック クリーナー サイクロン 強力吸引 充電式…

ベクトン・ディッキンソン BD BBL TM TSAII5%ヒツジ血液寒天培地 20枚 251239 (63-6526-90)|a1-shop

【国内正規品】【1年保証】KINUJO プロ ストレートアイロン Straight Hair IronKINUJO キヌージョ 絹女KP001コテ KINUJO PRO KINUJORPO…

【国内シェア&楽天No.1!】リファ カールアイロンプロ リファ公式店 ReFa CURL IRON PRO 正規品 ヘアアイロン アイロン コテ 1年保証 無料保証 プレゼント ツヤ 傷みにくい…

【歳末大感謝クーポンで2,380円】「連続週間1位」毛玉取り 電動 6枚刃 充電式 毛玉取り器 2段階調整 コードレス 240分稼働 ledパネル付き 毛玉クリーナー 安全装置 usb 充電式…

Incident ID: 650b71e3-bohn-45d6-93be-f3039f81deda IP Address : 219.104.25.38

【30日23:59終了セットイベント開催中】\新色登場/【公式】ドライヤー 速乾 大風量 乾くのに乾かない ブライト シャワードライヤー Brighte SHOWER DRYER 佐々木希 |…

2-6430-10 ぺたんチェック(R)10 SCD寒天培地 PT8010

未分類 暇をみてNO①寒天培地を作ってみました。 おすすめこのサイトについて